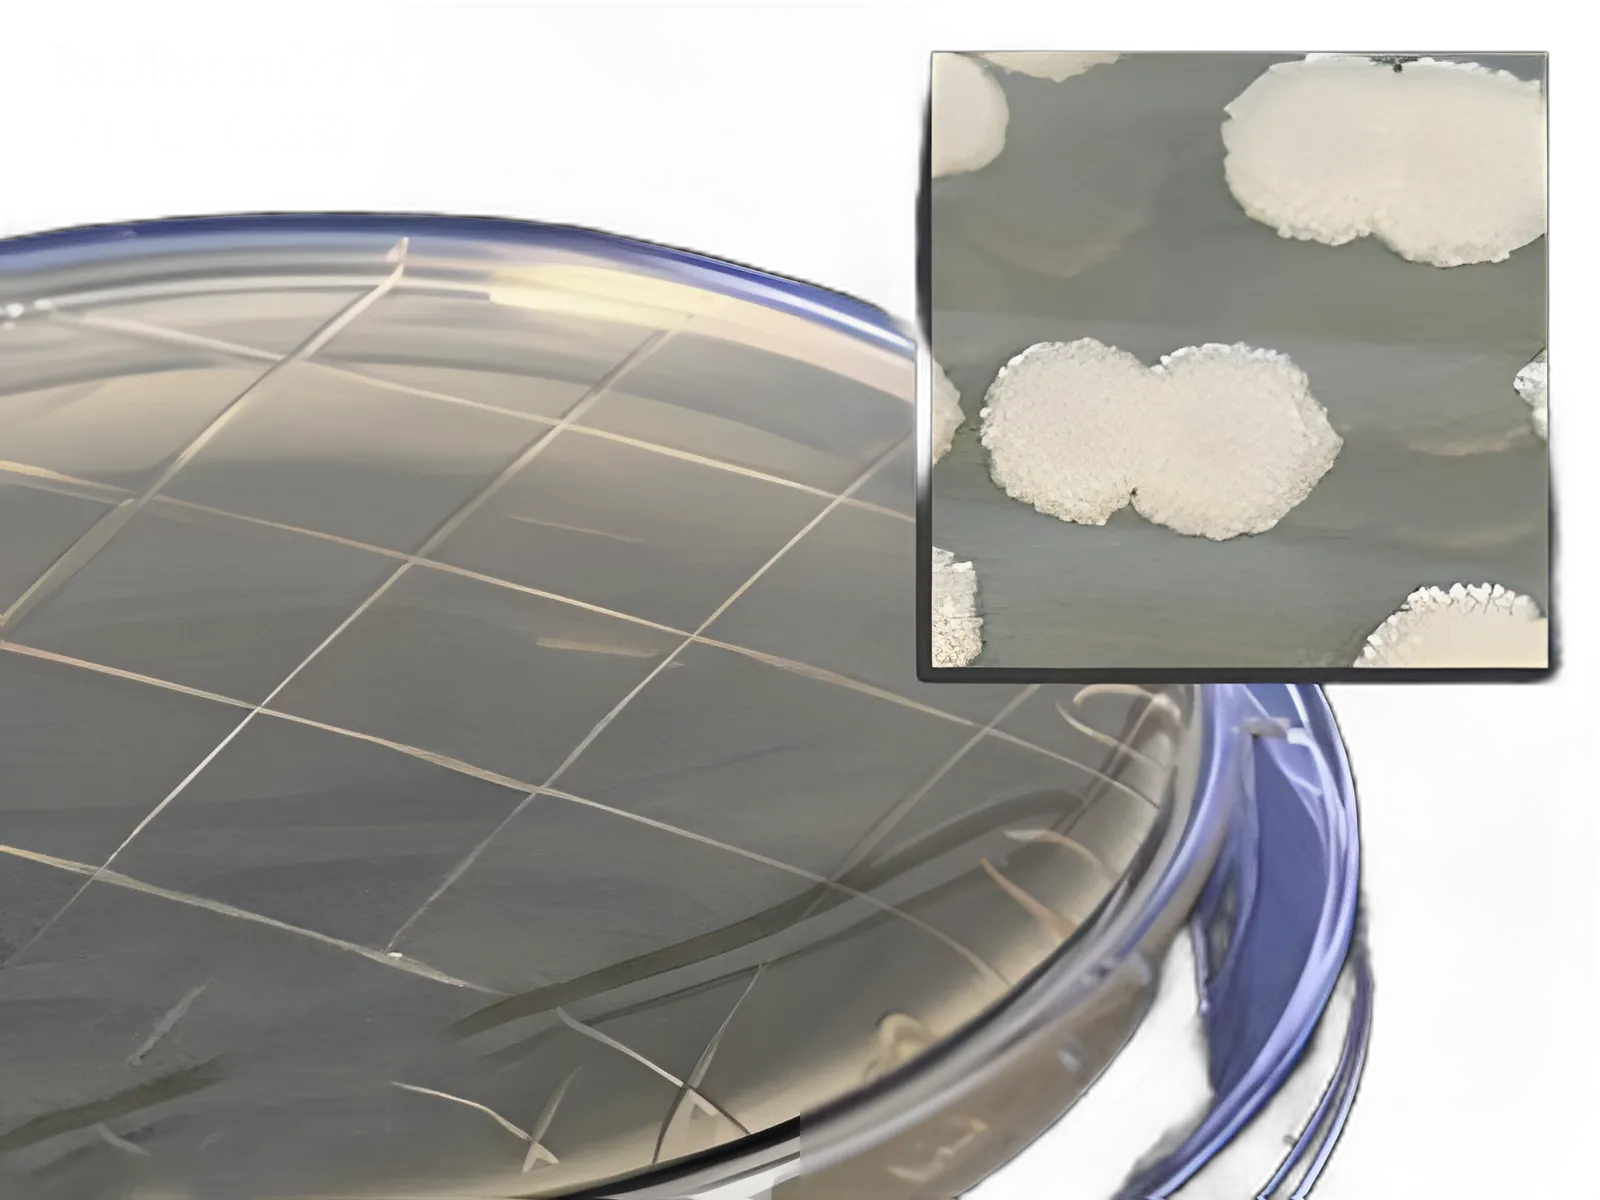
Prepared Media Lok-Tight™ Tryptic Soy Agar (TSA) Plates with Lecithin & Tween® 80 by Hardy Diagnostics

Compare
View Alternative
Prepared Media Lok-Tight™ Tryptic Soy Agar (TSA) Plates with Lecithin & Tween® 80 by Hardy Diagnostics
P34 | USAMP#79941169
dimensions
15 X 60 mm
Product Description
- Optimized for microbial limit testing, the Tryptic Soy Agar (TSA) with Lecithin and Tween® 80 contact plates are designed for efficient environmental monitoring, sterility testing, and microbial enumeration.
- Featuring the unique Lok-Tight™ friction lid with an optional locking mechanism, these plates ensure sample integrity during transportation and incubation.
- Each package contains 10 ready-to-use TSA plates, manufactured by Hardy Diagnostics, a leader in microbiological media.
- Formulated according to USP standards, making them ideal for pharmaceutical, food, and cosmetic industries.
- Refrigeration required to maintain stability and extend shelf life.
Product Specification
Manufacturer SKU
P34
Manufacturer
Hardy Diagnostics
Brand
Lok-Tight™
USAMP SKU
USAMP#79941169
Application
Prepared Media
UNSPSC Code
41106212
Country Of Origin
United States
Product Dating
USAMP Acceptable Dating: we will ship >= 21 days
Storage Requirements
Requires Refrigeration
Dimensions
15 X 60 mm
Type
Tryptic Soy Agar (TSA) with Lecithin and Tween® 80
Format
Contact Plate
Cultivation Or Test Type
For Cultivation and Enumeration of Microorganisms and Monitor Microbial Contamination
More Information
Locked
Base Price
$18.87
PK
🎯 Unlock Your Custom Tiered Price
15-35% bulk discounts
100+
units
10% OFF
$XX.XX
per unit
Save $XXX
Payment Terms
Priority Shipping
Custom Contract Pricing
250+
units
20% OFF
$XX.XX
per unit
Save $XXX
Payment Terms
Priority Shipping
Custom Contract Pricing
500+
units
30% OFF
$XX.XX
per unit
Save $XXX
Payment Terms
Priority Shipping
Custom Contract Pricing
Unlock Bulk Pricing
See pricing for all volume tiers
Instant access to volume pricing. Register free to compare all tiers and calculate your exact savings.
5,000+ verified buyers
Average savings:$23,400/year
15-35% OFF
for healthcare facilities on bulk orders
24/7 Live Chat!
Instant support anytime